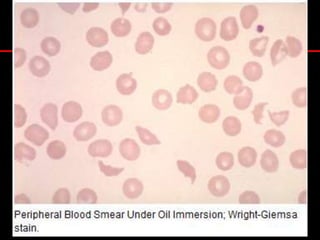
Historia.Hombre 23 años, sin antecedentes mórbidosInicio Abril 2006 (3m evol.)AsteniaFatigabilidadAnorexiaIctericia progresivaOrinas oscuras (no colúricas)
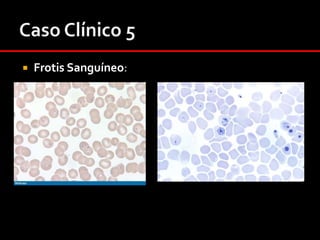
Al ingreso.DestacaHidratado – bien perfundido.Ictericia y palidez de piel y mucosas.Soplo sistólico eyectivo foco pulmonarBazo palpable

El documento presenta varios casos clínicos de anemias, destacando síntomas como fatigabilidad, disnea y hemorragias menstruales. Se discuten diagnóstico, exámenes de laboratorio y tratamientos para diferentes tipos de anemia, incluyendo anemia ferropriva y hemoglobinuria paroxística nocturna. También se abordan aspectos histopatológicos y complicaciones relacionadas con los trastornos hematológicos.






















































![Caso Clínico 1Corrección del Recuento de Reticulocitos:Recuento de Reticulocitos (%) x [Hto del paciente / 45]En el caso de la paciente: 3% x [24%/45%] = 1.8%La corrección del recuento de reticulocitos en este caso es menos del 2%.](https://image.slidesharecdn.com/hematologia-seminariodeanemia-091029173056-phpapp02/85/Seminario-De-Anemia-55-320.jpg)